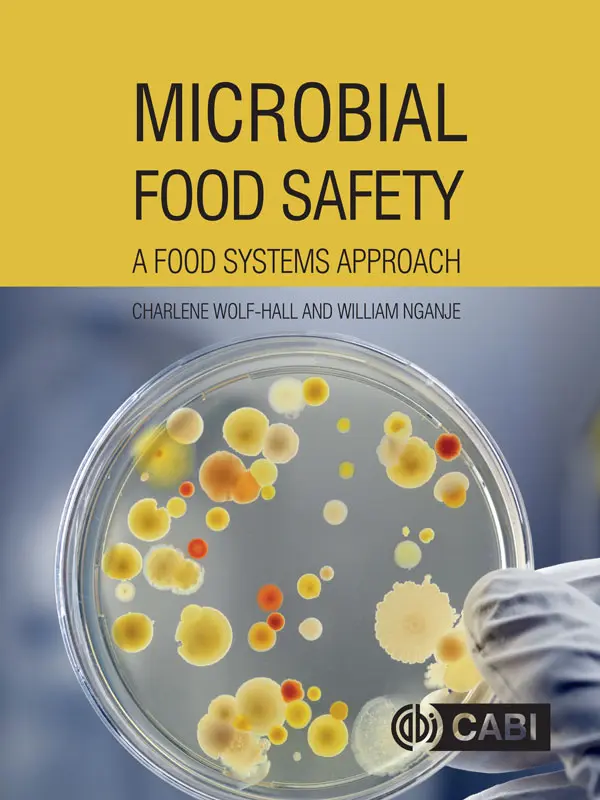
دانلود pdf کتاب ایمنی میکروبی غذا: رویکردی به سیستمهای غذایی

کتاب ایمنی میکروبی غذا: رویکردی به سیستمهای غذایی
Microbial Food Safety: A Food Systems Approach
شارلیِن ولف-هال (Charlene Wolf-Hall) و ویلیام انگنج (William Nganje)
چاپ اول، 2017
شابک (گالینگور): 9781780644806
شابک (شومیز): 9781780644813
شابک (ایبوک): 9781780644820
شابک (آنلاین): 9781786391971
ناشر: نشر CABI، ۲۰۱۷
تعداد صفحات: 192 صفحه
زبان: انگلیسی
ثبت سفارش ترجمه کتاب دامپزشکی فارسی به انگلیسی
ثبت سفارش چاپ کتاب دامپزشکی در داخل و خارج از کشور
معرفی کتاب ایمنی میکروبی غذا
این کتاب درسی میان رشتهای، اطلاعات حیاتی و پوشش جامعی از عوامل بیماریزای میکروبی منتقله از غذا که خطر بالقوهای برای مصرفکنندگان انسانی دارند، در اختیار خواننده قرار میدهد. این کتاب شامل عوامل بیماریزای انسانی و سموم ناشی از گیاهان، قارچها و محصولات حیوانی است و منشأ، خطر، پیشگیری و کنترل آنها را در نظر میگیرد.
نویسندگان از دیدگاه میکروارگانیسمها و انسانها، مفاهیمی از علوم اجتماعی و اقتصادی و همچنین میکروبیولوژی را در بر میگیرند و همافزاییهایی را برای یادگیری در مورد سیستمهای پیچیده غذایی به عنوان یک کل و هر مرحلهای که میتواند فرصتی برای کاهش خطر آلودگی میکروبی باشد، فراهم میکنند.
ایمنی میکروبی غذا: رویکردی به سیستمهای غذایی، مفاهیم را از طریق یک مدل شبکه تأمین غذا توضیح میدهد تا تعاملات بین نحوه انتقال غذا توسط انسانها در سیستم جهانی غذا و تأثیرات آن بر میکروارگانیسمها و سطوح خطر ایمنی میکروبی غذا را نشان دهد. این کتاب که در سراسر آن به صورت تمام رنگی ارائه شده است، موارد زیر را پوشش میدهد:
ویژگی های مشخصه کتاب ایمنی میکروبی غذا:
- به وضوح به صورت مطالب قابل فهم و در دسترس سازماندهی شده است.
- شامل سوالات کلیدی، خلاصهها، منابع مطالعاتی بیشتر و واژهنامهای برای کمک به تمرکز و مطالعه است.
- شامل کادرهای اطلاعاتی و مثالهای متعدد برای کمک به شما در مرور و بهکارگیری مفاهیم مطرحشده است.
مخاطبان کتاب ایمنی میکروبی غذا:
این کتاب که توسط نویسندگان مشهور در این زمینه و با تجربه تدریس گسترده نوشته شده است، علاوه بر متخصصانی که در این زمینهها کار میکنند، برای دانشجویان کارشناسی و کارشناسی ارشد رشتههای میکروبیولوژی مواد غذایی، ایمنی مواد غذایی و علوم غذایی در مقاطع بالاتر نیز مطالعهای ضروری است.
فهرست مندرجات کتاب ایمنی میکروبی غذا
بخش ۱. مبانی ماتریس غذا: عوامل درونی و بیرونی مؤثر بر میکروارگانیسمهای موجود در غذا
فصل ۱. غذا
فصل ۲. مفاهیم اکولوژیکی غذاها و تعریف قبل و بعد از برداشت
فصل ۳. عوامل درونی و بیرونی و غذاهای بالقوه خطرناک
فصل ۴. انسانها و میکروبها - تحلیل ریسک
بخش ۲. پاتوژنهای منتقله از غذا
فصل ۵. عفونتها، مسمومیتها منتقله از غذا و اتیولوژی
فصل ۶. باکتریهای گرم مثبت
فصل ۷. باکتریهای گرم منفی
فصل ۸. میکروارگانیسمهای یوکاریوتی نگرانکننده در غذا: انگلها و کپکها
فصل ۹. ویروسها و پریونها
بخش ۳. چگونه عوامل اجتماعی، نظارتی و اقتصادی میتوانند بر سطوح خطر میکروارگانیسمهای بیماریزا در غذا تأثیر بگذارند
فصل ۱۰. اقدامات کنترلی: مورد PR/HACCP
فصل ۱۱. هزینه شیوع بیماریهای میکروبی ناشی از غذا
فصل ۱۲. هزینه شیوع بیماریهای میکروبی ناشی از غذا برای جامعه
فصل ۱۳. هزینه و مزایای اقدامات کنترلی: ردیابی مواد غذایی
فصل ۱۴. تأثیرات بر تجارت و مقررات جهانی
واژهنامه
نویسندگان کتاب ایمنی میکروبی غذا:
نام: شارلیِن ولف-هال (Charlene Wolf-Hall)
افیلیشن: دپارتمان علوم دامپزشکی و میکروبیولوژی، دانشگاه ایالتی داکوتای شمالی، ایالات متحده آمریکا
نام: ویلیام انگنج (William Nganje)
افیلیشن: دپارتمان تجارت کشاورزی و اقتصاد کاربردی، دانشگاه ایالتی داکوتای شمالی، ایالات متحده آمریکا
مشخصات کتابشناختی:
- عنوان فارسی: ایمنی میکروبی غذا: رویکردی به سیستمهای غذایی
- عنوان انگلیسی: Microbial food safety : a food systems approach
- نویسنده: شارلیِن ولف-هال (Charlene Wolf-Hall) و ویلیام انگنج (William Nganje)
- شابک (گالینگور): 9781780644806
- شابک (شومیز): 9781780644813
- شابک (ایبوک): 9781780644820
- شابک (آنلاین): 9781786391971
- ناشر: بوستون، ماساچوست: CABI، [۲۰۱۷]
- تعداد صفحات: 192 صفحه
- زبان: انگلیسی
- موضوعات: | MESH: آلودگی مواد غذایی - پیشگیری و کنترل | آلودگی مواد غذایی - اقتصاد | میکروبیولوژی مواد غذایی | بیماریهای ناشی از غذا - اقتصاد | تجزیه و تحلیل سیستم ها

همتی –
برای خرید کتاب چاپی، ثبت سفارش ترجمه فارسی به انگلیسی دامپزشکی، اکسپت مقالات ISI، تبدیل پایان نامه به کتاب، استخراج مقاله از پایان نامه، دیزاین اسلاید دفاع پایان نامه، چاپ کتاب دامپزشکی در داخل و خارج از کشور؛ از طریق فرم تماس یا واتساپ با اپراتورهای ما در تماس باشید.